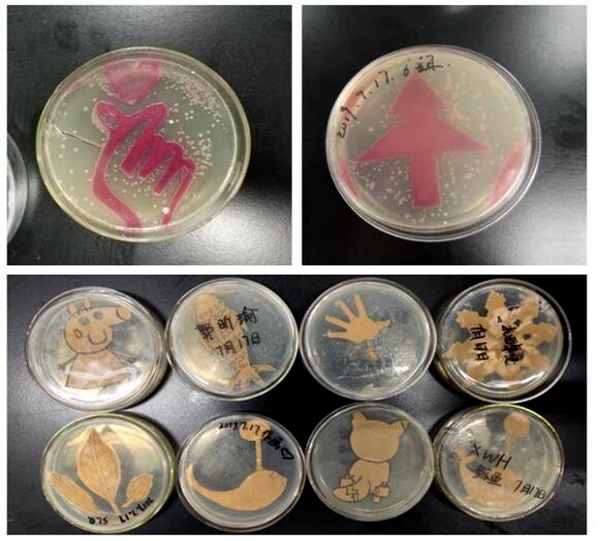

11月19日至22日,2019年青少年高校科学营总结研讨会在福建厦门召开。我校生命科学学院“‘大自然的颜料’——生活中的微生物培养与作画”荣获2019年青少年高校科学营特色营队活动。

会议由青少年高校科学营全国管理办公室、中国科协青少年科技中心主办,厦门大学、福建省科协承办。中国科协青少年科技中心副主任刘会强,中科院科学传播局领导班子成员、高级业务主管徐雁龙等领导和嘉宾出席会议。32个省级管理办公室及港澳台承办机构,53所高校分营、14个专题营和西部营代表,共150余人参加。全国管理办公室围绕2019年青少年高校科学营活动作工作报告,活动评估项目主管对2019年活动评估情况做总结汇报。
“‘大自然的颜料’——生活中的微生物培养与作画”活动以“认识大自然的颜料,探索微生物的奥秘”为主题开展,包含“生活中的微生物”专题报告、环境微生物检测、微生物作画、显色等内容。活动中利用大肠杆菌等生活常见微生物作菌种,按设计好的图案在培养基上“作画”,由于不同微生物的颜色有差异,“画作”会呈现出丰富的色彩。或利用紫外线致死微生物原理,用一定图案作为阴影遮盖进行微生物作画。本活动以丰富精彩的理论课程、生动有趣的实践操作将科学与艺术相结合,通过用微生物作画展现生命科学的魅力,提升学生科学兴趣,培养科学素养。
自2015年以来,我校作为青少年高校科学营分营先后承办5届科学营活动,累计接待全国各地共计1000余名高中生。学校将学术交流与实践引领相结合,围绕“从科学看生活”和“从生活看科学”两条探索路线,每年组织交流学习、参观体验、动手实践、体验大学生活等活动近20余场,充分发挥高校育人优势,帮助学生体验西农学科特色和大学文化,引导青少年走进科学、了解科学、崇尚科学,培养青少年的科学精神、创新意识和实践能力,将科学精神和西农精神植入人心,为培养科技创新后备人才打下坚实基础。
据悉,2019年青少年高校科学营活动以庆祝建国70周年为契机,按照“加强思想政治引领,服务国家战略,突出分营特色,增强活动内涵,不断提升社会影响力”的总体要求,统筹规划,科学设计,取得了显著的成效。活动共有海峡两岸暨港澳2080所中学含11200名高中生和780名带队老师参与,全国共组织68个分营,整个活动历时一个月。